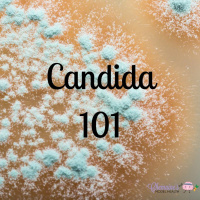
#119 Candida 101

Sinopsis
Biohacker, Personal trainer, Pilates instructor and Nutritional Therapist, specializing in orthomolecular nutrition, long term weight loss, anabolic growth, brain health and more ---- total human health optimization xo
Episodios
-
#127 Limitations to fat loss
26/06/2019 Duración: 36minThere are so many things that could be standing in the way of or slowing down your fat loss results --- so many things that people don't think of. So in this weeks podcast we look at the 'basics' of what could be limiting your fat loss. We discuss insulin, portions, nutrient deficiencies and of course stress and mindset. Enjoy and please feel free to share with someone who may benefit and help us reach the masses ;)
-
#126 Swelling, fluid retention and circulation
12/06/2019 Duración: 36minA lot of us can experience increased swelling and fluid retention at this time of year -- a few of my clients pop to mind. So I wanted to put together this podcast episode, to highlight the causes of swelling and puffiness, along with what I do and recommend to help with circulation and managing said swelling. *I forgot to mention in the episode that lymph drainage, massage and body brushing can be awesome for lymph congestion and improving circulation. I hope you find this informative and please do share with anyone you feel will benefit....this time of year can be tough for many with swelling and every little bit helps.
-
#125 Macronutrients 101 (for fat loss)
30/05/2019 Duración: 22minUnderstanding macronutrients and how to count them can seem daunting to many --- but its really not that hard at all. In this weeks episode we go through if counting macros is for you, how to do it and why it might be a great tool for you. As always please share with anyone you feel may benefit from the information in these podcast episodes :)
-
#124 The menstrual cycle for fat loss and muscle gain
22/05/2019 Duración: 24minIts not an uncommon question --- "does my menstrual cycle impact my fat loss or muscle gaining efforts?". The answer is YES, yes it does! In this weeks podcast I hope to shed a bit more light on this question and how to plan your training and nutrition around your menstrual cycle to optimize your fat loss results. As always, please share with anyone you feel may benefit and help us reach the masses :)
-
#123 Menstrual cycle 101
09/05/2019 Duración: 05minBelieve it or not --- not many females understand how their menstrual cycles works and I really wanted to lay the ground work this week for the follow up podcast next week on 'The menstrual cycle and weight loss'. Even if weight loss is not your goal, its super important to have a good understanding of how your body works because the majority of us want to be healthy regardless of our weight. Listen, enjoy and commit to being a life long learner for your body. Oh and remember sharing is caring ;)
-
#122 Understanding Salicylates
01/05/2019 Duración: 10minSalicylate load and intolerance can effect many people and your tolerance load can depend on ability to detoxify on a daily basis....but what are the symptoms of salicylate overload? Well there is headaches and migraines, inflammation, fatigue and mood issues like irritability to name a few. Check out this weeks podcast to uncover more of the causes and symptoms of a salicylate overload and what you can do to support your body.
-
#121 Detoxing or always Toxing
25/04/2019 Duración: 22minD E T O X I N G or always T O X I N G? This is a case of 'do you really understand whats going on in your body?'. It definitely that time of the year when more talk about detoxing is popping up as people hope to 'clean house' before summer. And because we detox DAILY, I feel it the perfect time to look at this topic and how to support our bodies detox properly.
-
#120 Insulin sensitivity and resistance 101
17/04/2019 Duración: 24minInsulin resistance --- Did you know that if you fat cells are insulin resistant you can actually lose fat? Most of us are insulin resistant on some level but most people don't understand exactly how insulin resistance works and effects different tissues. In this weeks podcast episode we look at the basics of insulin sensitivity and resistance throughout different parts of the body. And also how to TEST for resistance and start to improve it.
-
#119 Candida 101
10/04/2019 Duración: 22minCandida can be a nightmare for many people, but there are also many people that suffer with symptoms but are not aware that it might be Candida that's behind it all. In this weeks podcast episode we look at some of the symptoms of Candida and how we might start addressing them. This episode is packed with easy to understand information and tools that you can implement immediately. Remember, sharing is caring xo
-
#118 Hormones and body shape
03/04/2019 Duración: 23minA quick glance at a friend body tells you right away something is different right?! Her hips are different, maybe her tummy is flatter, butt is rounder and this can all tell us something. It gives us a bit of insight to what is happening with hormones and what may be the best fat loss protocol to take....but not only that, it tells us that one size does not fit all. This is one of the reasons I like to 'see' a client, so I can get an idea of where their body fat is distributed and combine that with a symptom picture so that we may find the best diet for their goals. Check out this weeks podcast to understand what your body shape and different fat storage sites on your body can mean for your hormone and fat loss plan. As always, sharing is caring ;)
-
#117 Eating simple for success
27/03/2019 Duración: 23minSome of my most successful clients eat S I M P L Y on a daily basis --- this does not negate the nutritional density or tastiness of the meal but definitely helps with their success. In this weeks podcast episode we look at - having a plan, making your meals functional on every level and how hyper stimulatory food choices make your journey tougher. As always, sharing is caring - if you know anyone that may benefit from this information, then please share. Lets all help make our world a healthier place.
-
#116 Combating Acne
19/03/2019 Duración: 19minAcne is something that roughly 85% of young adults have to deal with, even some of us in adulthood are subdued to this annoying manifestation, and the severity of the Acne determines the type of scarring you may be left with as a grown adult. There are so many factors such as Hygiene, diet and gut health, genetic make up and more…..which we look at more in depth in this weeks podcast. Remember sharing is caring, if you know just one person that may benefit from this information -- please share with them :)
-
#115 10 Rules for Fat Loss
13/03/2019 Duración: 28minSo yes there are many variables that can impact whether or not you lose FAT but in this podcast I give a 'general' guideline on 10 rules that will help get you in a good starting place to losing fat before the summer....can I get a WHOOP WHOOP? Be sure to take notes -- especially the little hack on how to decipher a label when in a jam! And remember, sharing is caring xo
-
#114 Eating frequency -- how often should you eat
06/03/2019 Duración: 25minSound familiar? --> "Then there's those people that end up binging at the end of the day...they have a small breakfast and lunch but they are trying to count calories, they think their metabolism works like a calculator and by the time they get home they have so much hunger, cravings and no energy, not even energy to fight cravings....not only do they not want to go out for a walk or do exercise but they eat dinner and keep eating until they pass out in a insulin coma and then repeat this the next day until they are in this big negative loop." How often should you eat?? Find out more on eating frequency in this weeks podcast and remember sharing is caring.
-
#113 Surviving menopause naturally
27/02/2019 Duración: 26minMenopause is a naturally occurring transition in a woman’s life. It is a period wherein women undergo a lot of changes in their bodies. In this weeks podcast we look at the symptoms of menopause, some short term add in to make this stage in your life a bit easier, what you want to do in the long term and we touch a bit on HRT or hormone replacement therapy. Check it out and remember sharing is caring, even if its just with one person that will benefit from this knowledge.
-
#112 Are you in peri menopause?
20/02/2019 Duración: 24minIn this weeks highly anticipated podcast episode we are looking at PERI MENOPAUSE. Are you in it? What are the symptoms? What happens during this time and what can you do to make this part of your journey a bit more enjoyable? Peri menopause can start anywhere from age 35 and onwards --- so I think this podcast will be super informative for all women (and even some men lol).
-
#111 The importance of being bile
13/02/2019 Duración: 15minIn this weeks podcast we are learning to understand our bile a bit better and how its super important to good health! "So your liver constantly makes bile, its constantly trickling out and if you have a gallbladder it gets store there and gets concentrated by up to 10 times then when u eat it gets pumped out to emulsify fats and you absorb or eliminate fats. But if you have no gallbladder, so you have had your gallbladder removed - your getting a constant trickle of bile out of the liver that goes straight into the bowels and its not concentrated 10 times. This means in a meal you can only tolerate about 1/10 of the amount of fat, this means you have to space your fat out and can't have one big fatty meal." Check out this weeks podcast to find out more xo
-
#110 Gallstones and the gallbladder
06/02/2019 Duración: 20minGallstones and gallbladder issues are prevalent in society now days --- The world gastroenterology organization calls is a 'Global burden'. Many will see no symptoms of gallstones and many will be inflicted with severe pain :( . In this weeks podcast we hope to shine a bit of light on what gallstones are, the stages and types of gallstones. And some natural preventative measures. Please be sure to share with anyone you feel may benefit for this information.
-
#109 How to choose a multivitamin
30/01/2019 Duración: 14minChoosing a MULTIVITAMIN can be a pain or even choosing a good quality supplement -- I'm constantly getting asked 'is this any good?'. So I put together a podcast episode that would help guide you though, whats a good form of a certain vitamin or mineral, and what to look for when purchasing a good multivitamin. Use this episode as a source of reference and please share with anyone you feel may benefit :)
-
#108 The missing link part 2
23/01/2019 Duración: 13minLast week in part 1 of The missing link we looked at what might be slowing down or putting handbrakes on your results....this week we put further emphasis on that missing link or the components you may be missing in your diet and lifestyle -- and how they are SO important for cellular health, hormones and thus fat burning. Remember sharing is caring! Please share with anyone you feel needs a little health support :).